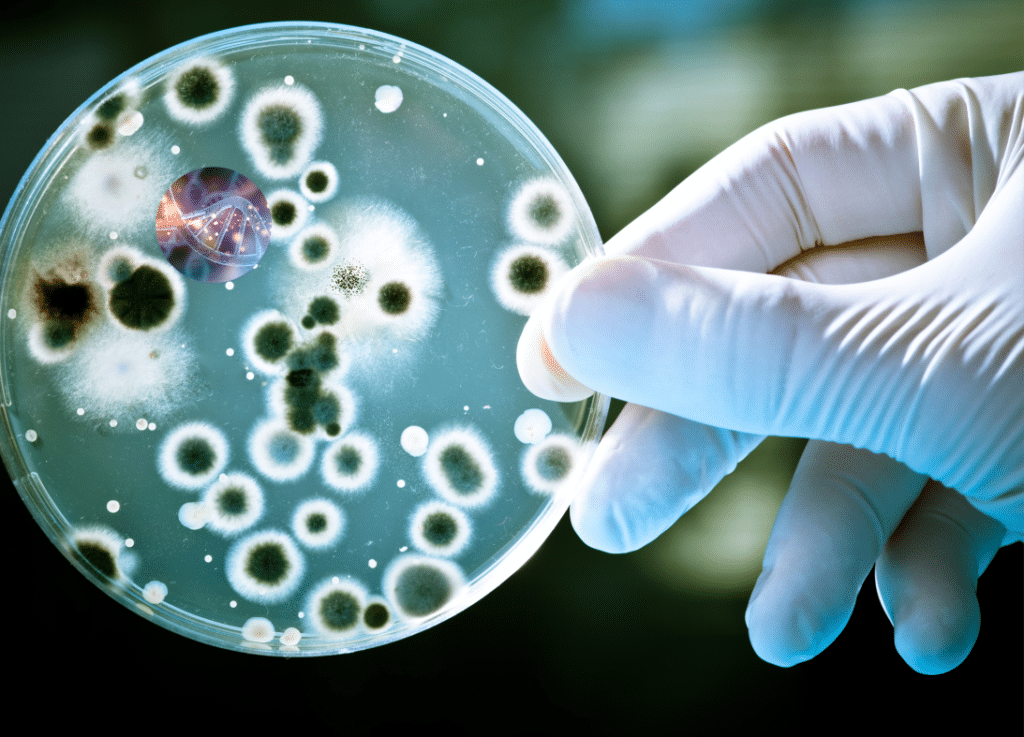

Gabriela Feix Pereira ¹, ²; Bibiana Braga ¹; Gertrudes Corção 2
1 DORF KETAL BRASIL LTDA., P&D, Nova Santa Rita, RS – Brasil. 2 Universidade Federal do Rio Grande do Sul, Departamento de Microbiologia, Porto Alegre, RS – Brasil.
(1) Introdução
Durante a extração e produção de petróleo, processos contendo água são propensos ao crescimento de microrganismos, e o crescimento descontrolado é um precursor de sérios problemas, como corrosão das estruturas metálicas, formação de biofilmes e geração de produtos metabólicos, como sulfeto de hidrogênio (H2S), que além de questões de saúde e segurança, pode prejudicar a qualidade do petróleo produzido.
A principal fonte de água durante os processos de extração e produção de petróleo é a água produzida. Essa água é extraída do poço em conjunto com o petróleo sob a forma de emulsão. Na plataforma, a emulsão é separada e a água produzida segue o processo de tratamento até ser enquadrada nos requisitos para descarte ou reinjeção no poço. A água produzida apresenta composição físico-química complexa e variável o que gera uma população de microrganismos diversa (Al-Ghouti et al., 2019).
Além da composição variável da água produzida, as condições extremas no processo de extração/produção, como alta temperatura, baixo oxigênio e alta salinidade selecionam os microrganismos mais adaptados. Os grupos de Bactérias Produtoras de Ácido (BPA) e Bactérias Redutoras de Sulfato (BRS) estão comumente presentes no microbioma de água produzida (Li et al., 2017). Como produto do metabolismo fermentativo, em condições de ausência ou baixo teor de oxigênio as BPA podem produzir diversos tipos de ácidos orgânicos e inorgânicos, que reduzem o pH da água, afetando as reações eletroquímicas e aumentando a taxa de corrosão do sistema. As BRS, na presença de sulfato ou outras fontes de enxofre e em condições de ausência ou baixo teor de oxigênio, geram H2S através do processo de respiração celular. O H2S é um gás tóxico, corrosivo e inflamável, razão de grande preocupação na indústria de petróleo.
Com base nessas informações, o objetivo deste estudo foi avaliar as diferenças na composição do microbioma de duas amostras de água produzida (AP 1 e AP 2), coletadas em dois distantes campos de petróleo brasileiros. A ação de biocidas na redução da concentração de BPA e BRS proveniente dessas amostras de água produzida foi avaliada. Os biocidas sulfato de tetrakis hidroximetil fosfônio (THPS) e Glutaraldeído foram utilizados, uma vez que são amplamente empregados no tratamento microbiológico da água produzida (Kahrilas et al., 2015; Korenblum et al., 2010).
(2) Materiais e Métodos
(2.1) Amostras de Água Produzida
Duas amostras de água produzida foram utilizadas neste estudo. A amostra AP1 foi coletada em um campo offshore localizado no sudeste brasileiro. A amostra AP2 foi coletada em um camo onshore localizado no nordeste brasileiro. As amostras foram mantidas refrigeradas e foram filtradas em filtros de 0,22 µm em até 72 h. Os filtros com os microrganismos retidos foram mantidos a -20°C até a análise.
(2.2) Análise da composição bacteriana das amostras de água produzida
(2.2.1) – Extração de DNA
O DNA genômico total foi extraído das amostras em duplicata com o kit DNEasy PowerSoil (Qiagen, Alemanha), seguindo as instruções do fabricante. O DNA extraído de cada amostra foi quantificado pelo fluorímetro Quantus (Promega, EUA) usando o kit dsDNA BR Asssay (Invitrogen, EUA).
(2.2.2) Amplificação e sequenciamento do gene 16S rRNA
A região V4 do gene 16S rRNA foi amplificada com os primers 515F (5´ GTGCCAGCMGCCGCGGTAA 3´) e R806 (5´ GGACTACHVGGGTWTCTAAT 3’), ambos modificados para conter uma região adaptadora Illumina (Caporaso et al., 2011). A amplificação do gene por PCR foi realizada pela mistura de ~100 ng de DNA genômico, 1,0 mM de MgCl2, 0,5 µM de cada primer, 0,2 mM de cada dNTP, 2U Platinum Taq DNA Polymerase High Fidelity (Life Technologies, EUA) e 1x tampão de reação. As condições de ciclagem térmica para amplificação foram uma desnaturação inicial (2 min a 94°C) seguida de 25 ciclos de desnaturação (45 s a 94°C, 45 s a 55°C e 1 min a 72°C) e uma extensão (6 min a 72°C) no equipamento Master cycler Personal 5332 Thermocycler (Eppendorf, Alemanha).
Os amplicons foram purificados usando esferas Agencourt AMPure XP (Beckman Coulter, EUA) seguindo as instruções do fabricante. O sequenciamento foi realizado na plataforma Illumina MiSeq (Illumina Inc., EUA) com um kit v2 500, que gera sequências de 250 pb. Os dados do sequenciamento foram processados usando o software QIIME 2 (Hassan et al., 2018). Todas as análises estatísticas foram realizadas usando scripts python implementados no QIIME 2. Após o agrupamento das unidades taxonômicas (OTU) com 97% de similaridade, o mapeamento foi realizado contra banco de dados RDP (Wang et al., 2007). As informações das sequências metagenômicas estão disponíveis no European Bioinformatics Institute (EBI) no banco de dados EBI Metagenômica com o número de acesso ERP121357.
(2.3) Cultura de BPA e BRS a partir das amostras de água produzida
As culturas de BPA e BRS provenientes das amostras de água produzida foram enriquecidas por 21 dias a 35°C. Ambas as culturas foram transferidas semanalmente (10% de inóculo) para frascos contendo meios de cultura estéreis. Para BPA foi utilizado o meio de cultura Caldo Vermelho Fenol com glicose 15 g·L-1 (Merck, Alemanha). Para BRS o meio Postgate B modificado (McKenzie & Hamilton, 1992; Postgate, 1984) foi utilizado. Antes do uso, os meios de cultura foram purgados com N2 para reduzir o teor de oxigênio.
(2.4) Concentração Inibitória Mínima (CIM) de biocidas nas culturas de BPA e BRS
Para avaliar a resistência das culturas de BPA e BRS aos biocidas Glutaraldeído e THPS, a CIM de cada biocida foi determinada. Um inóculo de 1% (v/v) e diferentes concentrações dos biocidas (50 a 1.000 mg·L-1) foram adicionados a microplacas de 96 poços contendo 200 µL de meio de cultura (Schug et al., 2020). Para a validação do teste foi utilizado um controle positivo de cada cultura, sem presença de biocida. A análise foi realizada em triplicata. As placas de micro titulação foram incubadas em jarra de anaerobiose contendo gerador de anaerobiose (Anaerobac, Probac, Brasil) por 72 h a 35°C.
(3) Resultados e Discussão
(3.1) Composição bacteriana das amostras de água produzida
A composição do microbioma na água produzida, assim como as características físico-químicas é variável, porém alguns filos bacterianos são comuns nestas amostras. Na maioria dos casos, Proteobacteria é o filo predominante e está amplamente distribuído em ecossistemas de campos petrolíferos, seguido por Firmicutes, Defferibacteres, Bacteroidetes, Actinobacteria e Thermotogae (Li et al., 2017). No caso deste estudo, a Figura 1 demonstra a abundância relativa dos filos bacterianos encontrados nas amostras analisadas. O perfil de distribuição de abundância dos filos encontrados é semelhante ao descrito em literatura para outras amostras de água produzida analisadas. Essa tendência pode ser explicada pelas condições extremas encontradas em campos petrolíferos, como a presença de hidrocarbonetos na água, alta salinidade e altas temperaturas. Em geral, esse ambiente é responsável por selecionar os microrganismos mais adaptados, mas grandes diferenças são visíveis apenas em termos de ordem e gênero.

Figura 1 – Abundância relativa de filos bacterianos nas amostras de água produzida.
Ao contrário dos filos, a composição de gêneros bacterianos variou significativamente entre as amostras de água produzida (Figuras 2A e 2B). Além disso, a diversidade de gêneros no microbioma da amostra AP2 foi maior do que a diversidade da AP1. Outro ponto de destaque é a alta abundância de gêneros desconhecidos na amostra AP2 (45%). A maior diversidade bacteriana e a predominância de gêneros bacterianos desconhecidos na amostra AP2 podem ser fatores de interferência na eficácia dos tratamentos com biocidas em campos de petróleo localizados em terra.

Figura 2 – Abundância relativa de gêneros bacterianos nas amostras de água produzida AP1 (A) e AP2 (B).
As amostras analisadas neste estudo demonstraram abundância de gêneros de BRS, compreendendo a ordem Desulfovibrionales, que foi dividida entre o gênero Desulfovibrio e outros gêneros não identificados, e o gênero Desulfonauticus. Apesar de cada amostra ter apresentado um perfil de abundâncias diferente entre filo/gêneros, no total, a abundância relativa de BRS nas amostras correspondeu a 28% em AP1 e 23% em AP2. BRS se desenvolvem na presença de sulfato, que usam como aceptor de elétrons na via de redução dissimulatória de sulfato para geração de energia (Muyzer & Stams, 2008; Qian et al., 2019). Entretanto, apesar da identificação da presença de sulfato nas amostras (3.314 mg·L-1 em AP1 e 692 mg·L-1 em AP2), esse não foi o único fator a modular a composição de BRS. Outros fatores, como temperatura, salinidade e competição bacteriana também influenciam na abundância (Li et al., 2017).
As amostras também apresentaram abundância significativa de bactérias do grupo BPA halofílicas e halotolerantes, como Halanaerobium e Halomonas, que são comumente encontradas em água produzida devido às condições de hipersalinidade. Halanaerobium, predominante em AP1 (30% de abundância relativa; Figura 2A) consiste em uma bactéria anaeróbia obrigatória e moderadamente halofílica que requer concentrações de NaCl entre 30.000 – 200.000 mg·L-1 para crescimento (Oren, 2014). Bactérias do gênero Halanaerobium são responsáveis pela redução do tiossulfato e têm demonstrado papel importante na catálise da corrosão do aço carbono, uma metalurgia comum em tanques, dutos e outras estruturas (Liang et al., 2014). A suscetibilidade desse gênero a biocidas foi avaliada em outro estudo, onde a bactéria Halanaerobium DL-01 foi exposta aos biocidas THPS e glutaraldeído e demonstrou a necessidade da utilização de altas concentrações de glutaraldeído (500 mg·L-1) e THPS (~ 406 mg·L-1) para inibição do crescimento (Liang et al., 2016).
O gênero Pelobacter é outro gênero comumente encontrado em água produzida (Vigneron et al., 2017). Esse gênero consiste em bactérias gram-negativas estritamente anaeróbicas, cujos membros são incapazes de fermentar açúcares e metabolizam apenas um número muito limitado de substratos. Espécies de Pelobacter desempenham papéis importantes na degradação fermentativa de substratos incomuns, como etanol e butanol, podendo usar enxofre (S°) como aceptor de elétrons nessas reações (Sun et al., 2010). Além disso, estudos indicam a associação de espécies de Pelobacter a bactérias metanogênicas na degradação de alcanos de petróleo bruto (Gray et al., 2011).
Bactérias não identificadas denominadas “outros” foram quantificadas em diferentes proporções em ambas as amostras. AP1 apresentou apenas 4% de bactérias não identificadas, enquanto AP2 apresentou 45%. O metagenoma complexo e as condições extremas e únicas encontradas em campos de petróleo podem ser as razões para o alto número de bactérias ainda não identificadas.
(3.2) Resistência das culturas de BRS e BPA aos biocidas
As culturas de BPA e BRS foram utilizadas para determinações da CIM do glutaraldeído e do THPS. A Tabela 1 apresenta os resultados obtidos após a avaliação. As respostas das culturas de BRS aos biocidas variaram, sendo o glutaraldeído a apresentar menor CIM em AP1 e o THPS em AP2. No caso de BPA, foi observada a necessidade de altas concentrações de ambos os biocidas (acima de 1.000 mg·L-1) para a inibição do crescimento, demonstrando um elevado nível de resistência a estas moléculas quando utilizadas sozinhas.
Tabela 1 – CIM do glutaraldeído e THPS em culturas de BRS e BPA provenientes de amostras de água produzida.

Os diferentes níveis de resistência em culturas bacterianas do mesmo grupo, mas com diferentes origens, demonstram a importância da análise caso a caso para a definição do tratamento microbiológico mais adequado.
(4) Considerações finais
Estudos sobre a composição bacteriana em campos de petróleo e seus impactos em diferentes áreas vêm sendo desenvolvidos ao longo dos anos, porém as interações entre a população bacteriana e a resistência biocidas precisam ser mais bem compreendidas. Neste estudo, apesar de estarem presentes em abundâncias distintas entre as amostras, os grupos de BRS e BPA foram predominantes. Como ambos os grupos são conhecidos pelo envolvimento na corrosão de estruturas metálicas, formação de biofilmes e geração de H2S (Li et al., 2017) e são os principais alvos bacterianos de biocidas, conclui-se que as duas amostras analisadas apresentavam elevado potencial de dano em plataformas.
As respostas das culturas de BRS e BPA aos biocidas variaram, e com isso destaca-se a necessidade de definição de tratamentos customizados, levando em consideração o nível de resistência da população existente no local de aplicação aos biocidas. Além disso, outras estratégias de aumento da eficiência de tratamentos microbiológicos podem ser utilizadas, como a aplicação de mais de um biocida com diferentes modos de ação, que amplia o espectro de ação e reduz a resistência bacteriana, e o monitoramento do tratamento para ajuste de dosagem e acompanhamento da eficiência.
(5) Referências
Al-Ghouti, M. A., Al-Kaabi, M. A., Ashfaq, M. Y., & Da’na, D. A. (2019). Produced water characteristics, treatment and reuse: A review. In Journal of Water Process Engineering. https://doi.org/10.1016/j.jwpe.2019.02.001
Caporaso, J. G., Lauber, C. L., Walters, W. A., Berg-Lyons, D., Lozupone, C. A., Turnbaugh, P. J., Fierer, N., & Knight, R. (2011). Global patterns of 16S rRNA diversity at a depth of millions of sequences per sample. Proceedings of the National Academy of Sciences, 108(Supplement 1), 4516–4522. https://doi.org/10.1073/pnas.1000080107
Gray, N. D., Sherry, A., Grant, R. J., Rowan, A. K., Hubert, C. R. J., Callbeck, C. M., Aitken, C. M., Jones, D. M., Adams, J. J., Larter, S. R., & Head, I. M. (2011). The quantitative significance of Syntrophaceae and syntrophic partnerships in methanogenic degradation of crude oil alkanes. Environmental Microbiology. https://doi.org/10.1111/j.1462-2920.2011.02570.x
Hassan, M., Essam, T., & Megahed, S. (2018). Illumina sequencing and assessment of new cost-efficient protocol for metagenomic-DNA extraction from environmental water samples. Brazilian Journal of Microbiology. https://doi.org/10.1016/j.bjm.2018.03.002
Kahrilas, G. A., Blotevogel, J., Stewart, P. S., & Borch, T. (2015). Biocides in Hydraulic Fracturing Fluids: A Critical Review of Their Usage, Mobility, Degradation, and Toxicity. Environmental Science & Technology, 49(1), 16–32. https://doi.org/10.1021/es503724k
Korenblum, E., Valoni, É., Penna, M., & Seldin, L. (2010). Bacterial diversity in water injection systems of Brazilian offshore oil platforms. Applied Microbiology and Biotechnology, 85(3), 791–800. https://doi.org/10.1007/s00253-009-2281-4
Li, X. X., Mbadinga, S. M., Liu, J. F., Zhou, L., Yang, S. Z., Gu, J. D., & Mu, B. Z. (2017). Microbiota and their affiliation with physiochemical characteristics of different subsurface petroleum reservoirs. In International Biodeterioration and Biodegradation. https://doi.org/10.1016/j.ibiod.2017.02.005
Liang, R., Davidova, I. A., Marks, C. R., Stamps, B. W., Harriman, B. H., Stevenson, B. S., Duncan, K. E., & Suflita, J. M. (2016). Metabolic Capability of a Predominant Halanaerobium sp. in Hydraulically Fractured Gas Wells and Its Implication in Pipeline Corrosion. Frontiers in Microbiology, 7, 988. https://doi.org/10.3389/fmicb.2016.00988
Liang, R., Grizzle, R., Duncan, K., McInerney, M., & Suflita, J. (2014). Roles of thermophilic thiosulfate-reducing bacteria and methanogenic archaea in the biocorrosion of oil pipelines. Frontiers in Microbiology, 5, 89. https://doi.org/10.3389/fmicb.2014.00089
McKenzie, J., & Hamilton, W. A. (1992). The assay of in-situ activities of sulphate-reducing bacteria in a laboratory marine corrosion model. International Biodeterioration & Biodegradation, 29(3–4), 285–297.
Muyzer, G., & Stams, A. J. M. (2008). The ecology and biotechnology of sulphate-reducing bacteria. In Nature Reviews Microbiology. https://doi.org/10.1038/nrmicro1892
Oren, A. (2014). The Order Halanaerobiales, and the Families Halanaerobiaceae and Halobacteroidaceae. In E. Rosenberg, E. F. DeLong, S. Lory, E. Stackebrandt, & F. Thompson (Eds.), The Prokaryotes: Firmicutes and Tenericutes (pp. 153–177). Springer Berlin Heidelberg. https://doi.org/10.1007/978-3-642-30120-9_218
Postgate, J. R. (1984). The Sulphate-Reducing Bacteria (2nd ed.). Cambridge University Press.
Qian, Z., Tianwei, H., Mackey, H. R., van Loosdrecht, M. C. M., & Guanghao, C. (2019). Recent advances in dissimilatory sulfate reduction: From metabolic study to application. In Water Research. https://doi.org/10.1016/j.watres.2018.11.018
Schug, A. R., Bartel, A., Scholtzek, A. D., Meurer, M., Brombach, J., Hensel, V., Fanning, S., Schwarz, S., & Feßler, A. T. (2020). Biocide susceptibility testing of bacteria: Development of a broth microdilution method. Veterinary Microbiology, 248, 108791. https://doi.org/https://doi.org/10.1016/j.vetmic.2020.108791
Sun, J., Haveman, S. A., Bui, O., Fahland, T. R., & Lovley, D. R. (2010). Constraint-based modeling analysis of the metabolism of two Pelobacter species. BMC Systems Biology. https://doi.org/10.1186/1752-0509-4-174
Vigneron, A., Alsop, E. B., Lomans, B. P., Kyrpides, N. C., Head, I. M., & Tsesmetzis, N. (2017). Succession in the petroleum reservoir microbiome through an oil field production lifecycle. ISME Journal. https://doi.org/10.1038/ismej.2017.78
Wang, Q., Garrity, G. M., Tiedje, J. M., & Cole, J. R. (2007). Naïve Bayesian classifier for rapid assignment of rRNA sequences into the new bacterial taxonomy. Applied and Environmental Microbiology. https://doi.org/10.1128/AEM.00062-07